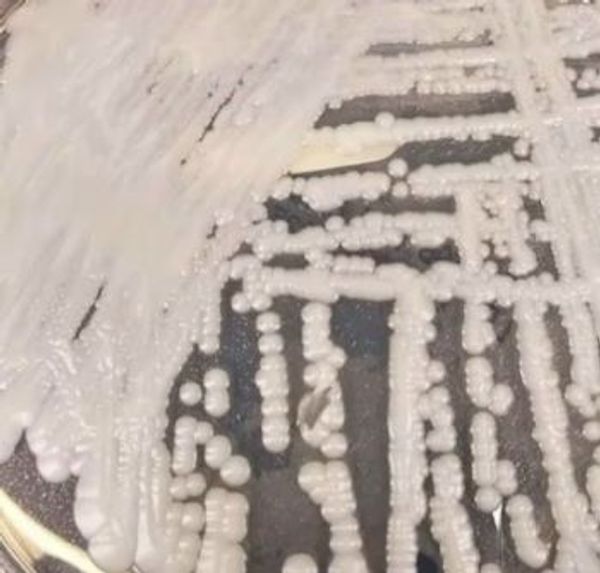

Candida Auris
Leestijd: 4 minutenKürzlich wurde von den Centers for Disease Control and Prevention (CDC) in Amerika ein beunruhigender Artikel über die Gefahr der Ausbreitung eines resistenten Schimmelpilzes, des Candida Auris, veröffentlicht. Die mögliche Folge dieser Ausbreitung könnte eine neue Pandemie sein.
Candida Auris
Candida Auris ist ein Schimmelpilz, der erstmals im Jahr 2009 entdeckt wurde. Er wurde bei einem siebzigjährigen Japaner gefunden und befand sich in seinem Ohr. Daher auch der Name: Candida = Pilz und Auris = Ohr. Der Pilz scheint sich in den letzten 15 Jahren weltweit ausgebreitet zu haben und scheint unempfindlich (resistent) gegen Medikamente zu sein, die zur Bekämpfung von Pilzen entwickelt wurden. Unempfindlichkeit ist bei Pilzen nicht üblich, weshalb Candida Auris auch als Superpilz bezeichnet wurde.
Der Ursprung dieses Pilzes ist bis heute unbekannt. Wahrscheinlich lebte der Schimmelpilz zunächst als Saprophyt - ein Pilz, der sich von verrottendem Material abgestorbener Pflanzen ernährt - und veränderte sich aufgrund des Klimawandels. Wahrscheinlich waren es Vögel, die den Schimmelpilz dann in Gebiete brachten, in denen Menschen leben. Inzwischen ist klar, dass Candida Auris von Mensch zu Mensch und über kontaminierte Oberflächen wie Türklinken und medizinische Geräte übertragen werden kann. Eine Übertragung über die Luft ist nicht möglich. Bisher findet die Ansteckung hauptsächlich in Krankenhäusern statt, wobei nur gefährdete Patienten mit geschwächtem Immunsystem erkranken. Eine Besonderheit ist, dass Candida Auris im Gegensatz zu anderen Pilzen längere Zeit außerhalb des Körpers überleben kann, so dass er durch Gegenstände wie Infusionen, Türklinken und Katheter übertragen werden kann.
Geschwächte Abwehrkräfte
Die meisten Menschen, die mit dem Schimmelpilz infiziert sind, erkranken nicht daran, weil das körpereigene Immunsystem ausreichend funktioniert. Wenn dieses Immunsystem jedoch geschwächt ist, zum Beispiel nach einer größeren Operation oder bei bestimmten Krankheiten, kann ein Mensch sehr schwer erkranken. Gefährlich wird es, wenn Candida Auris in die Blutbahn, das Herz oder das Gehirn gelangt. Hier kann er eine tiefe Infektion verursachen, mit Symptomen wie sehr hohem Fieber, Müdigkeit, Schüttelfrost und Muskelschmerzen.
Ist die Infektion erst einmal da, ist sie sehr schwer zu bekämpfen. Die Diagnose wird durch eine Blutkultur gestellt, die aus der Achselhöhle, der Leiste oder dem Gesäß entnommen wird. In einigen wenigen Fällen kann ein Antimykotikum helfen, das aber in der Regel nicht wirkt, da der Pilz resistent gegen Medikamente ist. Da es sich um einen Pilz handelt, kann kein Impfstoff entwickelt werden; dies ist nur möglich, wenn es sich um ein Virus oder ein Bakterium handelt. Bislang wurde festgestellt, dass 35 % der Patienten mit einer Candida Auris-Infektion im Blutkreislauf sterben.
In Deutschland gibt es zum Glück nur sehr wenige Patienten mit einer Candida Auris-Infektion. Die Wahrscheinlichkeit eines großflächigen Ausbruchs, wie wir ihn bei COVID-19 gesehen haben, wird daher als äußerst gering angesehen. Zusätzliche Maßnahmen sind daher nicht erforderlich. Das Tragen von Gesichtsmasken und das Halten von Abstand sind nicht wirksam. Das Einzige, was eine Ausbreitung verhindern kann, ist eine gute Hygiene, d. h. richtiges Händewaschen, insbesondere beim Besuch eines gefährdeten Patienten im Krankenhaus.

Die Gesundheitsbehörde wird die Entwicklungen rund um Candida Auris aufmerksam verfolgen in Zusammenarbeit mit anderen internationalen Instituten.
Sollten in Zukunft neue Informationen über Candida Auris bekannt werden, werden wir diesen Blog aktualisieren.